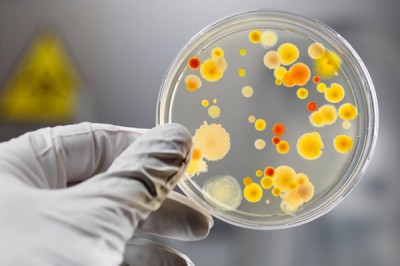
Вспышка сальмонеллеза в детском саду: число пострадавших выросло до 24 человек, очаг инфекции не найден

Очаг инфекции пока что не выявлен. При проведении эпидемиологического расследования были обнаружены многочисленные нарушения в пищеблоке дошкольного учреждения. Организовано медицинское наблюдение за всеми детьми, которые находились в контакте с заболевшими детьми.
Теперь руководству детского сада грозят серьезные кадровые перестановки.
– В данной ситуации возникает вопрос о халатности руководителя учреждения, потому что ситуацию начали купировать только через двое суток после того, как появился первый заболевший ребенок, – подчеркнула заместитель Председателя Правительства Иркутской области Валентина Вобликова.
Детский сад № 62 закрыт на карантин до 28 января, в понедельник будет решаться вопрос об открытии учреждения.
В связи с произошедшим планируется провести санитарное обследование пищеблоков в других детских учреждениях города и для обеспечения полной безопасности детей обеспечить максимальный контроль за питанием в школах и детских садах Иркутска.
По информации пресс-службы регионального правительства.
Источник: Источник фото

Комментарии
Для того чтобы оставить комментарий, вам необходимо войти на сайт